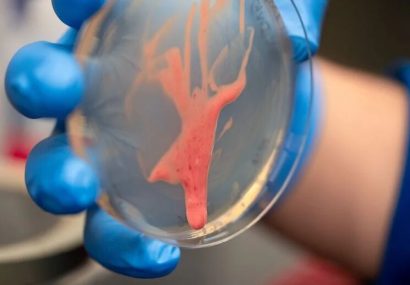
کشف راز یک قاتل نامرئی: این باکتری گیاهان را از پا درمی‌آورد

کشف راز یک قاتل نامرئی: این باکتری گیاهان را از پا درمیآورد
به گزارش واحد علم و فناوری خبرگزاری صبح اقتصاد وبگاه سایتِکدِیلی در گزارشی آورده است:
یک بیماری گیاهی که میتواند محصولات کشاورزی را تنها در عرض چند روز نابود کند، به طرز شگفتآوری به یک سازوکار ساده متکی است: مادهای چسبناک و روان که بیشتر شبیه لجن یا ژله رفتار میکند تا یک ماده جامد.
تحقیقات جدید نشان میدهد که این ماده غیرمعمول به باکتریهای رالستونیا (Ralstonia) کمک میکند تا با کارآیی ویرانگری در گیاهان حرکت کنند و باعث پژمردگی سریع گوجهفرنگی، سیبزمینی و بسیاری از محصولات مهم دیگر شوند.
یک عامل بیماریزای مرموز و صبور
این مطالعه که در مجموعه مقالات آکادمی ملی علوم آمریکا/ PNAS منتشر شده، حاصل همکاری پژوهشگران آسیبشناسی گیاهی و مهندسی در دانشگاه کالیفرنیا، دیویس است. گونهای خاص به نام رالستونیا سولاناسهآروم (Ralstonia solanacearum) به دلیل صبر و تحملش بسیار خطرناک است.
این باکتری میتواند سالها در خاک مرطوب زنده بماند بدون آنکه آسیب مشاهدهشدنی ایجاد کند؛ اما وقتی بالاخره به یک گیاه نفوذ میکند، بهسرعت در رگهای آبی گیاه حرکت میکند. نتیجه این حمله اغلب سریع و چشمگیر است: گیاهان آلوده تنها در عرض چند روز پژمرده میشوند و میمیرند.
تیفانی لاو پاور (Tiffany Lowe-Power)، استاد دانشگاه کالیفرنیا، میگوید: تشبیه من این است که آنها باعث حمله قلبی در گیاهان میشوند، زیرا رگها را مسدود میکنند و باعث پژمردگی و مرگ گیاه میشوند.
یک لایه محافظتی عجیبوغریب
رالستونیا مانند بسیاری از باکتریها، با ترشح یک پوشش محافظ به نام بیوفیلم از خود محافظت میکند. اما رفتار این پوشش با رالستونیا کاملاً متفاوت است. این ماده بهطور غیرمعمولی شُل و روان است و به باکتری کیفیت لزج و لجنی میدهد. لایه ترشحشده از یک مولکول بلند و شبیه قند به نام اگزوپُلیساکارید ۱ (exopolysaccharide 1) تشکیل شده است.
لاو پاور توضیح میدهد: با روشهایی که متخصصان میکروبشناسی و ژنتیک استفاده میکنند، توانستیم تا حدی به جواب نزدیک شویم، اما نه به سازوکار اصلی. ما به یک فیزیکدان نیاز داشتیم.
ورود فیزیک به میدان
هَری مَنیکانتان (Hari Manikantan)، استاد مهندسی شیمی که به مطالعه سیالات پیچیده علاقه دارد، وارد این پژوهش شد. او میگوید: من عاشق مطالعه موادی هستم که رفتارهای پیچیده و جالب دارند؛ موادی مانند بزاق، کف، مواد فعال سطحی ریه و حتی اشک. این مواد به ظاهر ساده، از قوانین فیزیکی شگفتانگیزی پیروی میکنند.
مانیکانتان توضیح میدهد: برخی مواد بسته به اینکه چقدر سریع به آنها نیرو وارد کنید، رفتار متفاوتی دارند. ممکن است در برابر یک ضربه ناگهانی مثل جامد سفت واکنش نشان دهند، اما در طول زمان مثل یک مایع غلیظ جریان یابند.
کشفی که پاسخ داد
با استفاده از تجهیزات آزمایشگاهی، پژوهشگران توانستند اندازهگیریهای دقیقی از ترشحات باکتری انجام دهند. آنها کشف کردند که این ماده لجنی بهراحتی زیر فشار و جریانی که در رگهای گیاه وجود دارد، جریان مییابد. این امر به باکتری اجازه میدهد بهسرعت در سراسر گیاه آلوده پخش شود.
متیو کوپآرگوئلو (Matthew Cope-Arguello)، دانشجوی تحصیلات تکمیلی، یک آزمایش ساده توسعه داد: اگر باکتریهای سازنده بیوفیلم را در یک ظرف کِشت رشد دهید و سپس ظرف را کج کنید، آیا ماده لجنمانند به صورت قطرهای میچکد؟
آنها دریافتند که این ویژگی منحصر به عوامل بیماریزای گیاهی است.
پیامدهای فراتر از یک رشته
این کشف بینرشتهای نه تنها به مبارزه با یک بیماری مخرب کشاورزی کمک میکند، بلکه پنجرهای جدید به سوی درک رفتار مواد پیچیده در طبیعت باز میکند. مانیکانتان میگوید: اکنون میتوانیم شروع به مدلسازی ریاضی این پدیده کنیم. این کشف هیجانانگیزی برای دنیای فیزیک ماده نرم است.
این پژوهش نشان میدهد که چگونه همکاری میان رشتههای مختلف علمی میتواند به حل مسائل پیچیده کمک کند و به درک ما از جهان طبیعی عمق بخشد.
- منبع خبر : ایرنا